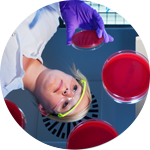

Geschichte des BfArM
1994
Mit der Auflösung des Bundesgesundheitsamtes entstehen drei eigenständige Einrichtungen, darunter das BfArM. Ihm werden die Aufgaben des Instituts für Arzneimittel übertragen.

Prof. Dr. Alfred G. Hildebrandt wird zum Direktor ernannt.
1995

Die "Europäische Agentur für die Beurteilung von Arzneimitteln" (EMEA) nimmt ihre Arbeit auf. Das BfArM als eine der bedeutendsten Zulassungsbehörden in der EU unterstützt die Agentur seither bei der wissenschaftlichen Beurteilung und Überwachung von Arzneimitteln, die in der EU zugelassen sind. Unsere Expertinnen und Experten sind in allen wissenschaftlichen Ausschüssen vertreten.
Mit Inkrafttreten des Medizinproduktegesetzes zur Umsetzung von EG-Richtlinien ergeben sich für das BfArM neue zentrale Aufgaben. Unter anderem erfasst und bewertet das Bundesinstitut seither sogenannte Vorkommnisse und prüft, wie Risiken beseitigt, verringert oder verhindert werden können. Auf diese Weise setzt es sich seither aktiv für die Sicherheit der Anwender auch im Bereich der Medizinprodukte ein.
Das Grundstoffüberwachungsgesetz (GÜG) tritt in Kraft. Es soll verhindern, dass Grundstoffe für die unerlaubte Betäubungsmittelherstellung verwendet werden. Dem BfArM werden für diese Überwachung des legalen Verkehrs mit diesen Stoffen zahlreiche Aufgaben übertragen.
1999

Erster Spatenstich für den Neubau des Instituts in Bonn.
Das BfArM zieht um: Rund 450 von 850 Arbeitsplätzen werden von Berlin in die Friedrich-Ebert-Allee 38 nach Bonn verlagert.
2000

Erste "BfArM im Dialog"-Veranstaltung. Das Institut greift in der Reihe seither regelmäßig Informationsbedarf auf und bindet Anspruchsgruppen frühzeitig in die Umsetzung ein. Das Format wird zu einem Erfolgsmodell und zeigt, dass sich Neuregelungen so meist schneller umsetzen lassen - ganz im Sinne der Patientensicherheit.
2001
Die Richtlinie 2001/83/EG zur Schaffung eines Gemeinschaftskodexes für Humanarzneimittel wird verabschiedet.
Anforderungen für die Durchführung von klinischen Prüfungen in der EU werden in der Richtlinie 2001/20/EG festgelegt.

Prof. Dr. Harald Schweim wird zum Präsidenten des BfArM ernannt.
Seit 2000 hatte er das Institut kommissarisch geleitet.
Schlüsselübergabe für den Institutsneubau an der Kurt-Georg-Kiesinger Allee 3 und Einweihung des bereits bezogenen ersten Bauabschnittes.
2002
Mit dem Substitutionsregister nimmt die Bundesopiumstelle ihre Tätigkeit zur Überwachung der Ersatztherapie bei Heroinabhängigkeit auf. Das Substitutionsregister leistet bis heute als bundesweites Überwachungsinstrument und Datenlieferant auf der Ebene von Bund, Ländern und Kommunen einen wichtigen Beitrag zum Patientenschutz und zur Sicherheit und Kontrolle im Rahmen der Substitutionsbehandlungen.
Errichtung der ersten Expertengruppe Off-Label am BfArM zur Beurteilung der Anwendung von Arzneimitteln außerhalb des zugelassenen Indikationsbereichs. Damit werden die Voraussetzungen dafür geschaffen, dass für die Patientinnen und Patienten frühzeitig neue, innovative Arzneimitteltherapien entsprechend dem Stand der wissenschaftlichen Erkenntnis in der gesetzlichen Krankenversicherung zur Verfügung stehen.
2003
Erste GCP-Inspektion außerhalb Europas unter Federführung des BfArM, um die Zuverlässigkeit der eingereichten klinischen Daten vor Marktzulassung des betreffenden Arzneimittels zu überprüfen. Expertinnen und Experten des BfArM sind seither regelmäßig als Inspektorinnen und Inspektoren klinischer Prüfungen in der ganzen Welt unterwegs.
2004

Prof. Dr. Reinhard Kurth wird zum kommissarischen Leiter des BfArM ernannt.
Erste Genehmigung einer klinischen Arzneimittelprüfung durch das BfArM im Rahmen der Umsetzung der europäischen Richtlinie 2001/20/EG. Seit 2004 müssen solche Studien in Europa behördlich genehmigt werden. So hat das BfArM sehr gute Einflussmöglichkeiten auf die Durchführung, was der Patientensicherheit und Forschungsfreiheit gleichermaßen zu Gute kommt. Mit rund 1.000 Anträgen pro Jahr nimmt das BfArM eine Spitzenposition unter den europäischen Arzneimittelbehörden ein.
2005
Inkrafttreten der Biosimilar-Gesetzgebung und Fertigstellung der ersten Biosimilar Guideline. Heute sind Biosimilars ein wichtiger Bestandteil der in der EU verfügbaren Behandlungsmethoden. Als Zulassungsbehörde setzt das BfArM hier klare Standards, um die sichere Versorgung der Patientinnen und Patienten zu gewährleisten.
Start des durch das BfArM initiierten und in der EU einzigartigen sogenannten Z.A.R.S.-Projektes. Dabei werden jährlich alle in Deutschland verfügbaren geeigneten Daten zur Resistenzsituation von derzeit circa 50 systemisch wirkenden Antibiotika erfasst und evaluiert. Das BfArM setzt sich dafür ein, dass die aktuelle Resistenzsituation in Deutschland sowie die Grenzwerte für die klinische Empfindlichkeit in den Fachinformationen der entsprechenden Arzneimittel adäquat abgebildet werden.
Einführung des Dezentralen Verfahrens (DCP) der Arzneimittelzulassung in der EU, bei der eine Zulassung für mehrere EU-Staaten gleichzeitig angestrebt wird. Expertinnen und Experten des BfArM arbeiten in diesem Zulassungsprozess bei der Europäischen Arzneimittel-Agentur (EMA) eng mit den europäischen Kolleginnen und Kollegen zusammen.

Beim BfArM erfolgt die erste Registrierung eines traditionellen pflanzlichen Arzneimittels in der EU.
Abschluss der Nachzulassung von Arzneimitteln, die vor Inkrafttreten des Arzneimittelgesetzes 1978 in Verkehr waren. Für diese Arzneimittel mussten pharmazeutische Unternehmen einen sogenannten "Nachzulassungsantrag" stellen, wenn das jeweilige Arzneimittel weiterhin verkehrsfähig bleiben sollte.
Verpflichtung zur elektronischen Anzeige von Verdachtsfällen schwerwiegender Nebenwirkungen von Arzneimitteln. die Meldungen sind wichtig, um Arzneimittelrisiken möglichst schnell zu identifizieren, da das BfArM dazu auf belastbare Daten und Risikosignale aus der Praxis angewiesen ist.
2006

Einrichtung der Kommission "Arzneimittel für Kinder und Jugendliche" (KAKJ) am BfArM. Die berät bei der Zulassung von Arzneimitteln, die (auch) für Kinder und Jugendliche vorgesehen sind. Das BfArM setzt sich konsequent dafür ein, die Arzneimittelsituation für Kinder und Jugendliche weiter zu verbessern.
Zulassung des ersten Biosimilars (Omnitrope, ein rekombinantes Wachstumshormon) in der EU. Seither haben die Vielfalt und Sensitivität entsprechender analytischer Methoden enorm zugenommen. Das BfArM hat einen großen Anteil an der Erstellung und Überarbeitung von Guidelines für die Biosimilarentwicklung.
2009
Durch das T-Register (T steht für "teratogen", das heißt "das ungeborene Kind im Mutterleib schädigend") überwacht die Bundesopiumstelle die Verschreibung und Abgabe von Arzneimitteln, die die Wirkstoffe Lenaliomid, Pomaliomid oder Thaliomid enthalten. Die Abgabe solcher Arzneimittel darf ab diesem Zeitpunkt ausschließlich auf die Vorlage eines gültigen T-Rezepts erfolgen.
Diamorphin (Heroin) wird für die Therapie von Schwerstabhängigen verfügbar.

Prof. Dr. Johannes Löwer wird zum Präsidenten des BfArM ernannt. Seit 2007 hatte er das Institut kommissarisch geleitet.
2010

Die erste Ausgabe des "Bulletin zur Arzneimittelsicherheit", herausgegeben durch BfArM und Paul-Ehrlich-Institut (PEI) erscheint. Die Publikation kommuniziert Arzneimittelrisiken zeitnah und mit Hintergründen und Vermittelt die Bedeutung der Überwachung vor und nach der Zulassung (Pharmakovigilanz). Das Bulletin zur Arzneimittelsicherheit erscheint seither vierteljährlich und informiert aus beiden Bundesoberbehörden zu aktuellen Aspekten der Risikobewertung von Arzneimitteln.
Neuregelung des Rechts der klinischen Prüfung von Medizinprodukten und Leistungsbewertungsprüfung von In-Vitro-Diagnostika in Deutschland. Eine klinische Prüfung von Medizinprodukten muss von der zuständigen Bundesoberbehörde genehmigt und von der zuständigen Ethik-Kommission zustimmend bewertet worden sein.

Prof. Dr. Walter Schwerdtfeger wird zum Präsidenten des BfArM ernannt.
2012
Die Definition für "Nebenwirkungen" ("adverse drug reaction") wird in der Mitgliedsstaaten der EU geändert: Als "Nebenwirkung" gelten nun auch Medikationsfehler, die eine Auswirkung auf die Betroffenen hatten, aber auch der Missbrauch von Arzneimitteln. Auch sie müssen nun an das BfArM gemeldet werden und dienen der kontinuierlichen Überwachung und Verbesserung der Arzneimittelsicherheit. Das BfArM bewertet und analysiert Berichte zu (potentiellen) Medikationsfehlern sowie zu Verdachtsmeldungen von unerwünschten Arzneimittelwirkungen im Zusammenhang mit Medikationsfehlern in einer eigenen Arbeitsgruppe "Arzneimitteltherapiesicherheit".
Aufbau einer eigenen Forschungsabteilung im BfArM und Etablierung dreier Forschungsschwerpunkte "Pharmakogenomik und Individualisierte Therapie", Pharmakoepidemiologie" und "Medizinproduktesicherheit". In der neu etablierten Forschungsabteilung beleuchtet das BfArM flankierend zu seinen regulatorischen Aufgaben weitere wichtige Fragen der Sicherheit und Wirksamkeit von Arzneimitteln und Medizinprodukten.
Der Ausschuss für Risikobewertung im Bereich der Pharmakovigilanz (PRAC) bei der EMA wird gegründet. Er ist für die Überwachung und Bewertung der Arzneimittelsicherheit für Humanarzneimittel auf europäischer Ebene zuständig. Expertinnen und Experten des BfArM leisten dabei einen wesentlichen Beitrag. Im Oktober 21018 wurde Dr. Martin Huber aus dem BfArM zum Stellvertretenden Vorsitzenden dieses Ausschusses gewählt.
Auch Patienten und Verbraucher können Nebenwirkungen an das BfArM und das PEI melden, wobei die Meldung in jeder Form erfolgen kann. Hierdurch können zusätzliche Erkenntnisse über die Sicherheit von Arzneimitteln gewonnen werden. Das BfArM bietet dazu auf seiner Internetseite speziell für Verbraucher konzipierte Meldewege an.
2013

Ein freiwilliges Meldeverfahren von Lieferengpässen wird für Zulassungsinhaber eingeführt und ein Register für gemeldete Lieferengpässe auf der Homepage des BfArM veröffentlicht. Das Register ist eine wichtige Grundlage dafür, Lieferengpässen differenziert begegnen zu können. Mit der Veröffentlichung schafft das BfArM außerdem noch mehr Transparenz und verbessert den Informationsfluss.
Das BfArM und das Bundesamt für Verbraucherschutz und Lebensmittelsicherheit (BVL) rufen die "Gemeinsame Expertenkommission zur Einstufung von Stoffen" ins Leben. Auslöser war, dass Stoffe, die vorwiegend oder ausschließlich in Arzneimitteln verwendet wurden, vermehrt als Lebensmittel oder Lebensmittelzutaten in Verkehr gebracht wurden.
Die "Leitlinie zur Bezeichnung von Arzneimitteln" wird veröffentlicht. Ziel ist es, Verwechslungen und Fehlanwendungen aufgrund unklarer, irreführender und verharmlosender Namen künftig verlässlich auszuschließen. Das BfArM setzt sich damit für den Schutz der Patientinnen und Patienten vor irreführenden Arzneimittelbezeichnungen ein.
Noch mehr Transparenz bei unerwünschten Arzneimittelwirkungen: Das BfArM bietet einen Online-Zugang zu seiner Datenbank mit Verdachtsmeldungen unerwünschter Arzneimittelwirkungen an. Damit steht Ärzten und Patienten eine weitere Möglichkeit offen, sich vertieft über Arzneimittelrisiken zu informieren.

Die Bundesopiumstelle führt das fälschungssichere Betäubungsmittelrezept ein und bringt mit dem elektronischen Abgabebelegverfahren die sichere Patientenversorgung und effiziente Verwaltung voran. Mit dem neuen Verfahren ermöglicht das BfArM eine jährliche Bürokratiekosteneinsparung von 124 Millionen Euro. Pro Jahr werden von der Bundesopiumstelle rund 13 Millionen Betäubungsmittelrezepte ausgegeben.
2014

Prof. Dr. Karl Broich wird zum Präsidenten des BfArM ernannt.
2015
Das BfArM wird neue Mitgliedseinrichtung des Deutschen Zentrums für Infektionsforschung (DZIF) und unterstützt es in seiner Forschungstätigkeit. Das Zentrum koordiniert translationale Infektionsforschung in Deutschland und richtet sie strategisch aus. Ziel der Kooperation ist, dass bereits in der frühesten Entwicklungsphase die Forschung zu neuen Antiinfektiva zielgerichteter und effektiver erfolgen kann.
Die Erwartungen der Patientinnen und Patienten werden mit Blick auf regulatorische Entscheidungen immer wichtiger. Sie nehmen eine Schlüsselrolle bei der Umsetzung und Optimierung von Behandlungsstrategien ein und sind nicht zuletzt auch Ideengeber neuer Verfahren. Deshalb etablieren BfArM und PEI den Dialog mit Patientenvertretenden und unterstützen die Interessenvereinigung dabei, ihre Expertise auch auf europäischer Ebene in Gremien einzubringen, die sich mit der Nutzen-Risiko-Bewertung von Arzneimitteln befassen.
Das BfArM startet ein Pilotprojekt zur "Bearbeitung von Anträgen klinischer Prüfungen mit Humanarzneimitteln entsprechend der Verordnung (EU) 536/214 unter gleichzeitiger Berücksichtigung der gesetzlichen Vorgaben von AMG und GCP-V. Eine wesentliche Änderung ist die gemeinsame und zeitgleiche Bewertung eines Antrags durch die zuständigen Stellen eines Mitgliedstaates. Ziel des Pilotprojekts ist, sich auf diese gemeinsame Bewertung vorzubereiten.
2016
Erster "Jour Fixe" zum Thema Liefer- und Versorgungsengpässe unter Beteiligung des BfArM und der Fachkreise. Er soll bestehende und sich abzeichnende Lieferengpässe bewerten und geeignete Maßnahmen vorschlagen. Das BfArM steht dabei im intensiven Austausch mit allen beteiligten Akteuren - einer von vielen Schritten hin zu einer flächendeckenden Information über Lieferengpässe. Der "Jour Fixe" findet seither regelmäßig im BfArM statt.
Erste europaweite Kampagne aller EU-Arzneimittelbehörden, in der Patientinnen und Patienten aufgefordert werden, Nebenwirkungen zu melden. Das BfArM appelliert dabei an die Bürgerinnen und Bürger, Verdachtsfälle zu melden und damit einen wichtigen Beitrag zur Arzneimittelsicherheit zu leisten.

Das neue Logo "Blaue Hand" kennzeichnet sogenanntes angeordnetes und behördlich genehmigtes Schulungsmaterial. Das neue Logo soll den Adressaten, also Ärzten und ggf. Apothekern und Patienten, erleichtern, das Schulungsmaterial zu erkennen. Damit werden diese verlässlicher erreicht, wodurch die Arzneimittelsicherheit weiter verbessert wird.
2017
Das BfArM beteiligt sich aktiv an der Umsetzung des "Global Health Protection Programme" des Bundesministeriums für Gesundheit (BMG GHPP). Durch die Schulung von Fachpersonal in Bonn und die Umsetzung von Promotionsprojekten in Afrika leistet das Institut einen wichtigen Beitrag zur Verbesserung der Arzneimittelversorgung. Ziel ist es, antimikrobielle Resistenzen zu bekämpfen.
Berufung der W2-Professur "Pharmakoepidemiologie" gemeinsam mit der Rheinischen Friedrich-Wilhelms-Universität Bonn.

Gründung des BfArM-Innovationsbüros, das Start-ups gezielt bei der Entwicklung neuer Arzneimittel und Medizinprodukte unterstützt. Das BfArM trägt auf diese Weise dazu bei, dass vielversprechende neue Arzneimittel und Medizinprodukte durch eine frühzeitige Beratung und Unterstützung gefördert werden und nicht an der fehlenden regulatorischen Erfahrung scheitern. Das Innovationsbüro hilft auf diese Weise, eine gute medizinische Versorgung der Patientinnen und Patienten auch in Zukunft sicherzustellen.

Das Gesetz zur Änderung betäubungsmittelrechtlicher und anderer Vorschriften tritt in Kraft. Damit werden die Möglichkeiten zur Verschreibung von Cannabisarzneimitteln deutlich erweitert. Mit Inkrafttreten des Gesetzes errichtet das BfArM eine Cannabisagentur. Ziel ist es, die Versorgung schwerkranker Patientinnen und Patienten künftig mit in Deutschland angebautem Cannabis in pharmazeutischer Qualität sicherzustellen.
BfArM, PEI und G-BA tragen mit einem gemeinsamen Beratungsangebot dazu bei, dass möglichst alle relevanten arzneimittelrechtlichen und sozialversicherungsrechtlichen Gesichtspunkte frühzeitig bei der Planung und Durchführung klinischer Prüfung berücksichtigt werden können, damit aussagekräftige Evidenz für Zulassung und Zusatznutzenbewertung generiert werden kann. Mit einem gemeinsamen Leitfaden werden pharmazeutische Unternehmer fokussiert über Zielsetzung, Beantragung und Ablauf der Beratungsangebote informiert.
Europäische Zulassungsinhaber müssen alle Verdachtsfälle zu unerwünschten Arzneimittelwirkungen direkt in das Informationssystem EudraVigilance der EMA einspeisen. Mit der Umstellung treten weitreichende Änderungen der Anzeigepflichten in Kraft. So müssen auch Nebenwirkungen gemeldet werden, die nicht schwerwiegend sind.
2018
BfArM-Zulassungsexperte Dr. Harald Enzmann wird zum Vorsitzenden des Ausschusses für Humanarzneimittel bei der EMA (CHMP) gewählt. Der Ausschuss bewertet neue Arzneimittel und spricht Empfehlungen für oder gegen deren gesamteuropäische Zulassung an die Europäische Kommission aus. Er gehört zu den höchsten wissenschaftlichen Gremien der EMA.
2019
Die Fälschungsschutzrichtlinie tritt in Kraft. Neue Sicherheitsmerkmale und eine zusätzliche Echtheitsprüfung sind wichtige Schritte für die Patientensicherheit und für mehr Transparenz im Arzneimittelverkehr.
Digitalisierung: Das BfArM geht mit der Roadshow des health innovation hub des BMG aktiv auf die eHealth-Gründerszene zu. Mit gezielter Hilfestellung bei regulatorischen Fragen, beispielsweise bei vielversprechenden Medizinprodukten wie Medical Apps, trägt das BfArM mit dem Innovationsbüro dazu bei, dass innovative Produkte für Patientinnen und Patienten schneller zur Verfügung stehen.

Big Data: Um die Anwendungssicherheit von Medizinprodukten weiter zu verbessern, bringt das BfArM neue Analysemethoden auf den Weg. Mit automatisierten Tools zur datengestützten Signal-Erkennung können die Wissenschaftlerinnen und Wissenschaftler des BfArM zukünftig noch mehr Erkenntnisse über Risiken gewinnen.
Ein weiteres gutes Signal für die bestehende Kooperation zwischen dem BfArM und der Universität Bonn: Prof. Dr. Werner Knöss übernimmt im Fachbereich Pharmazie die Professur für den Bereich "Drug Regulatory Affairs" und im Weiterbildungsstudiengang "Master of Drug Regulatory Affairs" die Funktion des Studiengangleiters.
2020
Das BfArM und das Deutsche Institut für Medizinische Dokumentation und Information (DIMDI) werden unter dem Dach des BfArM zu einer Behörde zusammengeführt. Die Ressourcen und Expertise beider Behörden werden gebündelt um so die Chancen, die sich durch die vielfältigen Entwicklungen im Gesundheitswesen ergeben, bestmöglich im Sinne der Patientinnen und Patienten zu nutzen. Synergieeffekte kommen dabei unter anderem mit Blick auf die Digitalisierung im Gesundheitswesen zum Tragen, hier wird beispielsweise die Aufgabenwahrnehmung in den Bereichen E-Health und neuer Technologien gestärkt.